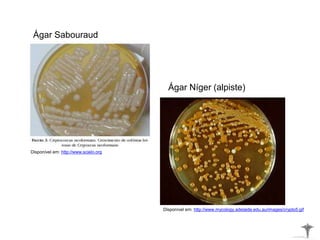
Ágar Níger (alpiste)
Ágar Sabouraud
Disponível em: http://www.scielo.org
Disponível em: http://www.mycology.adelaide.edu.au/images/crypto5.gif
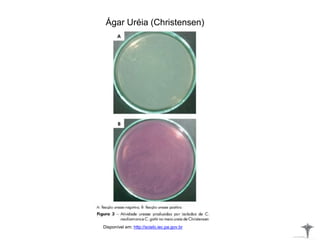
Ágar Uréia (Christensen)
Disponível em: http://scielo.iec.pa.gov.br

O documento aborda o diagnóstico laboratorial da criptococose, uma infecção fúngica associada ao sistema nervoso central e frequentemente relacionada à AIDS. Destaca a ecologia do fungo Cryptococcus neoformans, as manifestações clínicas, os métodos de diagnóstico e as opções de tratamento para humanos e animais. A prevenção da doença envolve evitar o contato com pombos, que são portadores do fungo.